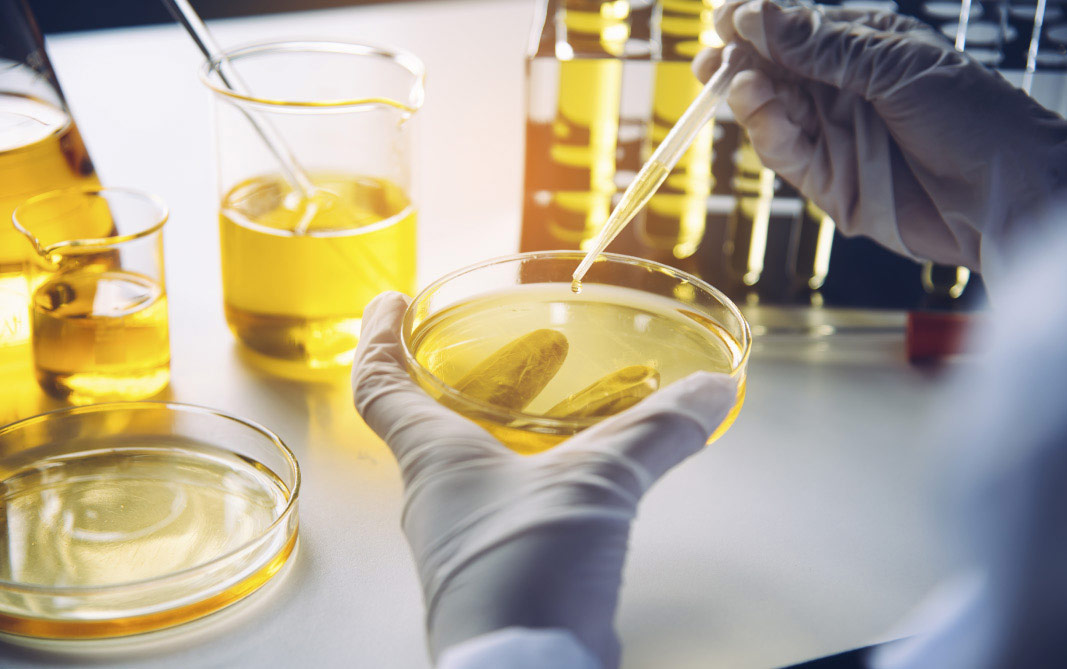

분야별 종합 연구개발
RESEARCH & DEVELOPMENT
6대 전문 기술
Our Professional Laboratories

프래그런스 실험실
Fragrance Lab
국제조향사가 직접아로마를 연구개발 하고 브랜드만의 향을 만들어냅니다.

스킨테스트 실험실
Skin Tests Lab
민감도및 자극 테스트로 민감도와 자극성을 도출하고 실제 포뮬러기능성을 평가합니다.

바이오기술실험실
Biotechnology Lab
에센셜 오일 성분의 유효성 확보를 위한
생물학적 구조 및 스크리닝 실험을
수행합니다.

프로세스 과기 실험실
Process Technology Lab
혁신적인 포장과 안정적인 기술 프로세스를 적용하여 고객에게 우수한
제품 품질을 제공합니다.

포뮬러 개발실험실
Formulation Lab
임상 아로마테라피 권위와 피부과학
전문가가 공동으로 다양한
유지법을 개발합니다.
안전검측실험실
Stability Testing Lab
엄격한 표준화된 테스트 절차를 통해
생산 프로세스 및 제품 품질
관리를 진행합니다.
전문 컨설팅 팀
Our Professional Team
심이사
- 영국IFA 아로마테라피총장급
- 영국IFA 360시간 아로마테라피 인증서
- 미국NAHA 레벨 I = II 강사
- 대형 체인 스파 전용 조향사
- 많은 유명 연예인들이 지정한 조향사
- "24절기-메르디앙 아로마테라피를 통한 자기치유 백과사전", "아로마테라피" 저자


레아윤
- 약학연구소 약학박사
- 현임 전문대학 부교수
- 약사 면허 소지
- 영국 IFA 국제 아로마테라피 실무자 자격증
- 미국 NAHA 국제 아로마테라피 협회 인증

이월묘
식물학 전문가

진소정
천연약물학전문가

동익유
뷰티마케팅분석전문가

임가정
트레이닝기획전문가
관련도서 및 팟캐스트
Related Books And Podcast






